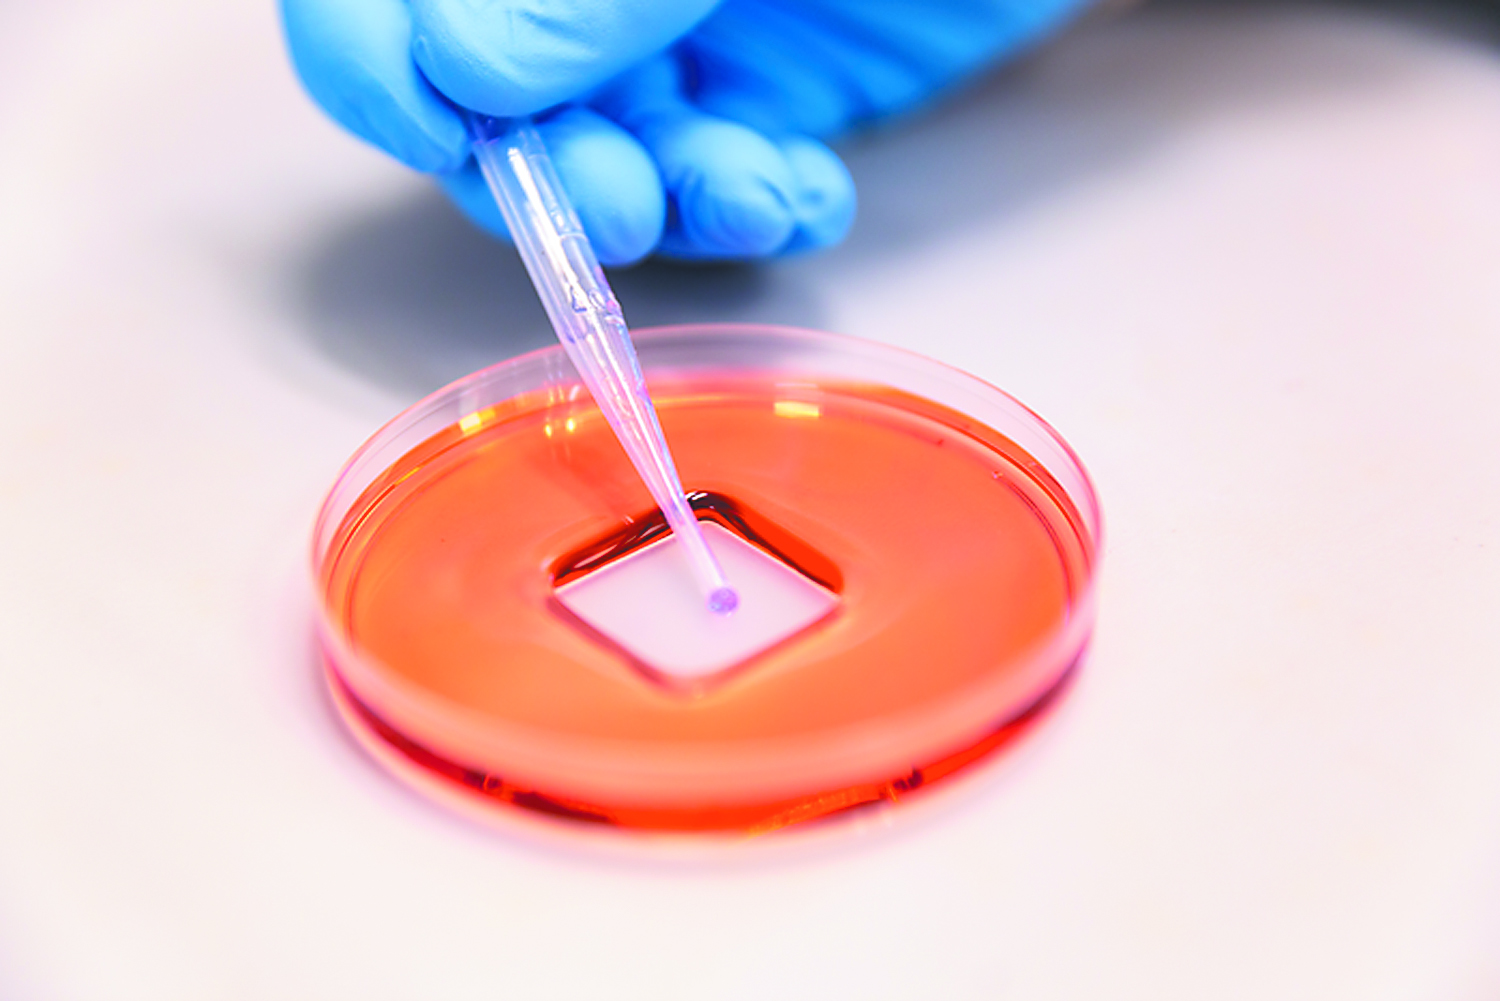

Οι μεγάλες κρίσεις γεννούν μεγάλες ιδέες και αυτό αποδεικνύεται περίτρανα στη μεγάλη, συνεχιζόμενη κρίση δημόσιας υγείας που περνά εδώ και πάνω από δυόμισι έτη η ανθρωπότητα. Οσο μεγάλη είναι η μάχη με την πανδημία που δεν λέει να κοπάσει τόσο μεγάλη είναι και η επιστημονική και ερευνητική παραγωγή που έχει ως στόχο να φέρει πιο κοντά το τέλος της τρέχουσας πανδημικής συνθήκης, δημιουργώντας παράλληλα μια πολύτιμη παρακαταθήκη ενάντια στους επόμενους εν δυνάμει πανδημικούς εχθρούς.
Πλήθος ερευνητικών ομάδων ανά τον κόσμο εργάζονται ακούραστα καθ’ όλο το πανδημικό διάστημα – εξ ου και η ερευνητική παραγωγή ενάντια στην COVID-19 έχει φθάσει σε επίπεδα-ρεκόρ – σε πολλά επίπεδα, από την πρόληψη ως τη διάγνωση και τη θεραπεία της νόσου που έχει κοστίσει ήδη εκατομμύρια ζωές και συνεχίζει να κοστίζει καθημερινά και άλλες.
Ενα απάνθισμα από πρόσφατα τέτοια ερευνητικά «άλματα» θα σας παρουσιάσουμε σήμερα, τα οποία ελπίζεται ότι θα μας βοηθήσουν να κάνουμε το… μεγάλο άλμα που θα μας φέρει μπροστά από τον SARS-CoV-2 αντί να βρισκόμαστε συνεχώς στο κατόπι του.

ΠΡΟΛΗΨΗ
Εισπνεόμενο εμβόλιο στρατηγικής σημασίας
Ενα εισπνεόμενο εμβόλιο που καταργεί τις βελόνες και βασίζεται σε έναν βακτηριοφάγο, τον Τ4 (οι βακτηριοφάγοι ή απλά φάγοι είναι μια ειδική κατηγορία ιών που προσβάλλουν βακτήρια), αποδείχθηκε αποτελεσματικό ενάντια στον SARS-CoV-2 σε πειράματα σε ποντίκια. Το εμβόλιο που αναπτύχθηκε από ειδικούς του Καθολικού Πανεπιστημίου της Αμερικής στην Ουάσιγκτον και του Πανεπιστημίου του Τέξας παρουσιάστηκε στην επιθεώρηση «mBio». Οι ερευνητές χορήγησαν στα ζώα μέσω της ρινικής οδού δύο δόσεις του εμβολίου με χρονική απόσταση 21 ημερών μεταξύ τους. Οπως είδαν, παρήχθη ισχυρή ανοσία στους βλεννογόνους της μύτης καθώς και ισχυρή συστημική αντισωματική και κυτταρική ανοσολογική απόκριση. Συγκεκριμένα το εισπνεόμενο εμβόλιο επήγαγε την παραγωγή υψηλών τίτλων εξουδετερωτικών αντισωμάτων ενάντια σε πολλές παραλλαγές του SARS-CoV-2 ενώ οδήγησε σε αύξηση των επιπέδων των T ανοσοκυττάρων CD4+ και CD8+ αλλά και σε υψηλούς τίτλους ανοσοσφαιρίνης Α (IgA, τάξη αντισωμάτων που παίζει σημαντικό ρόλο στην τοπική ανοσία των βλεννογόνων) στα ζώα στα οποία χορηγήθηκε.
Ηταν μάλιστα αξιοσημείωτο ότι όλες οι παράμετροι της ανοσολογικής απόκρισης ήταν καλύτερες όταν το εμβόλιο χορηγήθηκε σε εισπνεόμενη μορφή παρά όταν χορηγήθηκε ενδομυϊκά σε μορφή ένεσης.
Επιπροσθέτως το εισπνεόμενο εμβόλιο παρείχε στα πειραματόζωα πλήρη προστασία ενάντια στο στέλεχος SARS-CoV-2 MA10 (αντίστοιχο του SARS-CoV-2 που πλήττει τους ανθρώπους αλλά προσαρμοσμένο στα… ποντικίσια δεδομένα) καθώς και ενάντια στο αρχικό στέλεχος της Γουχάν και στο πιο επικίνδυνο στέλεχος Δέλτα. Στα πλεονεκτήματα του νέου εμβολίου περιλαμβάνονταν επίσης το ότι δεν διατάρασσε το μικροβίωμα του εντέρου καθώς και το ότι μπορούσε να συντηρηθεί σε θερμοκρασία δωματίου. «Το εισπνεόμενο εμβόλιο επάγει ανοσία στους βλεννογόνους των ποντικών καθώς και ισχυρή χυμική και κυτταρική ανοσολογική απόκριση. Παρέχει πλήρη προστασία και ανοσία ενάντια στις παραλλαγές του SARS-CoV-2. Είναι ένα εμβόλιο σταθερό, χωρίς ανοσοενισχυτικά και η διαδικασία παραγωγής και διανομής του αναμένεται να είναι αποδοτική από οικονομική άποψη. Ολα αυτά το καθιστούν ένα στρατηγικής σημασίας εμβόλιο επόμενης γενιάς ενάντια στην COVID-19 προκειμένου να μπει ένα τέλος στην τρέχουσα πανδημία» σημείωσαν οι ερευνητές και προσέθεσαν ότι η νέα πλατφόρμα εμβολίου που ανέπτυξαν μπορεί να αποδειχθεί «θησαυρός» και για το μέλλον ενάντια στους επόμενους εν δυνάμει επιδημικούς ή πανδημικούς «εχθρούς».
Αντιμικροβιακό σπρέι «θωρακίζει» τις επιφάνειες
Η νέα… ψεκαζόμενη επικάλυψη προσφέρει μια ανώτερη εναλλακτική σε σχέση με τα κλασικά απολυμαντικά, τα οποία απαιτούν τακτική εφαρμογή μέσα στην ημέρα
H πρώτη του είδους της επίστρωση σε μορφή σπρέι η οποία «θωρακίζει» τις επιφάνειες από επιμόλυνση με βακτήρια και ιούς – συμπεριλαμβανομένου του SARS-CoV-2 – για μεγάλο διάστημα χρόνου αναπτύχθηκε από αυστραλούς ερευνητές.
Το νέο σπρέι που περιγράφεται στην επιθεώρηση «Advanced Science» έχει διττή «δράση»: απωθεί τους ιούς και τα βακτήρια μέσω ενός φραγμού αέρα ενώ ταυτοχρόνως σκοτώνει τα παθογόνα μέσω υλικών σε… μικροκλίμακα τα οποία πιάνουν δουλειά αν η επίστρωση καταστραφεί σε κάποια σημεία ή μείνει βυθισμένη σε νερό για μεγάλα χρονικά διαστήματα. Το σπρέι περιέχει έναν συνδυασμό πλαστικών τόσο ισχυρών ώστε να θεωρούνται εναλλακτικά του θωρακισμένου γυαλιού.
Σύμφωνα με τους ειδικούς του Πανεπιστημίου του Σίδνεϊ στους οποίους ανήκει το επίτευγμα, η νέα… ψεκαζόμενη επικάλυψη προσφέρει μια ανώτερη εναλλακτική σε σχέση με τα κλασικά απολυμαντικά τα οποία απαιτούν τακτική εφαρμογή μέσα στην ημέρα και αποτελεί τη μόνη μόνιμη επίστρωση η οποία αποδεικνύεται ότι προστατεύει τις επιφάνειες από την επιμόλυνση με ιούς και άλλα παθογόνα χωρίς να προκαλεί παρενέργειες.
Η επικάλυψη, αναφέρουν οι ερευνητές, θα μπορεί να εφαρμοστεί σε επιφάνειες δημόσιων χώρων όπως τα κουμπιά του ασανσέρ, οι κουπαστές στις σκάλες, οι επιφάνειες εντός νοσοκομείων, οίκων ευγηρίας, σχολείων και εστιατορίων για την πρόληψη της εξάπλωσης κοινών ιών και βακτηρίων.
Οπως τα φύλλα του λωτού
Οπως σημείωσε ο καθηγητής στη Σχολή Επιστήμης Υλικών και Βιοϊατρικής Μηχανικής του Πανεπιστημίου του Σίδνεϊ, εκ των κύριων συγγραφέων της μελέτης, Αντόνιο Τρίκολι, η εξάπλωση ιών και βακτηρίων μέσω της επαφής με μολυσμένες επιφάνειες αποτελεί κύρια αιτία λοιμώξεων παγκοσμίως. Επιπροσθέτως η επιμόλυνση των επιφανειών με παθογόνους μικροοργανισμούς παίζει σημαντικό ρόλο στην εμφάνιση βακτηριακών στελεχών ανθεκτικών στα αντιβιοτικά. «Χωρίς να υπάρχει “φραγμός”, ιοί όπως οι κορωνοϊοί μπορούν να παραμείνουν στις επιφάνειες και να είναι μολυσματικοί έως και για μία εβδομάδα. Αλλοι ιοί, όπως οι ρεοϊοί οι οποίοι προκαλούν κοινό κρυολόγημα ή διάρροια, μπορούν να παραμείνουν επάνω στις επιφάνειες για αρκετές εβδομάδες προκαλώντας επιδημικά ξεσπάσματα σε νοσοκομεία και γηροκομεία».
Η νέα επίστρωση λειτουργεί όπως ένα φύλλο λωτού, εξήγησε ο καθηγητής Τρίκολι. «Το σπρέι δημιουργεί ένα στρώμα το οποίο απωθεί το νερό. Με δεδομένο ότι τα παθογόνα αγαπούν το νερό, παραμένουν παγιδευμένα στα σταγονίδια του νερού και η επιφάνεια προστατεύεται από επιμόλυνση. Αν ο μηχανισμός αυτός δεν δουλέψει, υπάρχει και δεύτερη γραμμή άμυνας: προκαλείται η έκλυση ιόντων από προσεκτικά σχεδιασμένα νανοϋλικά που περιέχονται στην επικάλυψη».
Η ερευνητική ομάδα δοκίμασε τη μηχανική σταθερότητα της επικάλυψης καθώς και την ικανότητά της να ανθίσταται στην επιμόλυνση με ιούς και βακτήρια – για αυτόν τον λόγο την εξέθεσε σε υψηλές συγκεντρώσεις παθογόνων.
Τα δείγματα βυθίστηκαν σε νερό για μεγάλο διάστημα χρόνου και οι επικαλυμμένες με το σπρέι επιφάνειες υπέστησαν επί τούτου φθορές ώστε να αποδειχθεί πόσο η επίστρωση μπορούσε να κρατήσει μακριά τα παθογόνα.
Στο πλαίσιο της συγκεκριμένης μελέτης εξετάστηκαν μεταλλικές επιφάνειες. Σε προηγούμενες μελέτες της όμως η ομάδα είχε δείξει ότι το σπρέι μπορεί να εφαρμοστεί σε οποιαδήποτε επιφάνεια όπως στυπόχαρτο, πλαστικό, τούβλα, πλακάκια, γυαλί. Με βάση τα ευρήματα των δοκιμών, η επίστρωση προλαμβάνει ως και το 99,94% της ανάπτυξης βακτηρίων ενώ μειώνει κατά 11 φορές την επιμόλυνση των επιφανειών από ιούς.
Η εφαρμογή του σπρέι είναι πολύ απλή – γίνεται με τον ίδιο τρόπο που εφαρμόζονται οι μπογιές σε σπρέι. Η ερευνητική ομάδα έχει ήδη ιδρύσει μια νεοφυή επιχείρηση με στόχο να καταστεί το αντιμικροβιακό σπρέι εμπορικά διαθέσιμο, πιθανώς μέσα στην επόμενη τριετία.
Επίθεμα 11 φορές πιο αποτελεσματικό από τη βελόνα

Πολλές υποσχέσεις δίνει η αυστραλιανή έρευνα για το εμβόλιο με επίθεμα
Εμβόλιο σε επίθεμα vs «παραδοσιακού» εμβολίου με βελόνα: σημειώσατε 1. Αυτό ανέφεραν ούτε λίγο ούτε πολύ ερευνητές του Πανεπιστημίου του Κουίνσλαντ στην Αυστραλία οι οποίοι διαπίστωσαν ότι ένα εμβόλιο που χορηγείται σε μορφή επιθέματος είναι αποτελεσματικότερο ενάντια στις παραλλαγές του SARS-CoV-2 όπως η Ομικρον και η Δέλτα σε σύγκριση με τα εμβόλια με βελόνα που όλοι γνωρίζουμε.
Η σχετική μελέτη που δημοσιεύθηκε στην επιθεώρηση «Vaccine» πραγματοποιήθηκε σε συνεργασία με την αυστραλιανή εταιρεία βιοτεχνολογίας Vaxxas. To εμβόλιο που χορηγείται με τη μορφή επιθέματος – μέσω 5.000 μικροσκοπικών προεξοχών που κολλούν στο δέρμα – είναι το Hexapro, το οποίο βασίζεται σε μια σταθεροποιημένη εκδοχή της πρωτεΐνης-ακίδας που εντοπίζεται στην επιφάνεια του SARS-CoV-2. Οπως ανέφερε ο δρ Κρίστοφερ Μακ Μίλαν από το Πανεπιστήμιο του Κουίνσλαντ, «το επίθεμα που βασίζεται σε μικροσυστοιχίες υψηλής πυκνότητας αποτελεί μια πλατφόρμα η οποία επιτυγχάνει χορήγηση του εμβολίου στις στιβάδες του δέρματος που είναι πλούσιες σε ανοσοκύτταρα». Ο ερευνητής σημείωσε ότι «ανακαλύψαμε πως ο εμβολιασμός μέσω επιθέματος ήταν περί τις 11 φορές πιο αποτελεσματικός στην εξουδετέρωση της παραλλαγής Ομικρον σε σύγκριση με τη χορήγηση του ίδιου εμβολίου μέσω της παραδοσιακής “μεθόδου της βελόνας”».
Ο δρ Μακ Μίλαν προσέθεσε μάλιστα ότι τα ευρήματα φάνηκε να ισχύουν και για άλλα εμβόλια εκτός από το Hexapro. «Μέχρι στιγμής, κάθε τύπος εμβολίου που δοκιμάσαμε με το επίθεμα, συμπεριλαμβανομένων DNA εμβολίων, εμβολίων με εξασθενημένο ιό καθώς και συζευγμένων εμβολίων επήγαγε ανώτερη ανοσολογική απόκριση σε σύγκριση με τις παραδοσιακές μεθόδους εμβολιασμού με βελόνα». Σύμφωνα με τους ερευνητές του Πανεπιστημίου του Κουίνσλαντ, τα επιθέματα δεν είναι μόνο αποτελεσματικότερα ενάντια στις αναδυόμενες παραλλαγές αλλά και πιο «φιλικά» στη χορήγηση σε σύγκριση με τα εμβόλια που φέρουν βελόνα.
Η ομάδα βρίσκεται τώρα σε φάση προετοιμασίας κλινικών δοκιμών. Μάλιστα η εταιρεία Vaxxas κατασκευάζει μονάδα παραγωγής στο Μπρισμπέιν με στόχο την εμπορική διάθεση εμβολίων που θα χορηγούνται σε μορφή επιθέματος τόσο για την τρέχουσα όσο και για μελλοντικές πιθανές πανδημίες.
H μάσκα που εξουδετερώνει τις πρωτεΐνες-ακίδες του ιού
Mια μάσκα προσώπου η οποία συλλαμβάνει και εξουδετερώνει την πρωτεΐνη-ακίδα του SARS-CoV-2… άμα τη εμφανίσει της ανέπτυξαν ερευνητές του Πανεπιστημίου του Κεντάκι με επικεφαλής τον καθηγητή του Κολεγίου Μηχανικής Ντιμπακάρ Μπαταχαρία.
Ο SARS-CoV-2 φέρει στην επιφάνειά του πρωτεΐνες-ακίδες οι οποίες του επιτρέπουν να εισέρχεται στα κύτταρα του ξενιστή. Η ερευνητική ομάδα ανέπτυξε, όπως ανέφερε στην επιθεώρηση «Communications Materials» του ομίλου Nature, μια ειδική μεμβράνη που περιέχει πρωτεολυτικά ένζυμα τα οποία προσδένονται στις πρωτεΐνες-ακίδες και τις εξουδετερώνουν. «Το νέο υλικό φιλτράρει τον ιό όπως μια μάσκα ΝΚ95 αλλά παράλληλα περιέχει αντι-ιικά ένζυμα που τον εξουδετερώνουν πλήρως. H καινοτομία αυτή αποτελεί άλλη μια “ασπίδα προστασίας” ενάντια στην εξάπλωση του SARS-CoV-2» ανέφερε ο δρ Μπαταχαρία και προσέθεσε ότι ανοίγει τον δρόμο και για προστασία ενάντια σε άλλους ιούς.
Η νέα… αντι-COVID μεμβράνη δοκιμάστηκε σε πρωτεΐνες-ακίδες του SARS-CoV-2 οι οποίες είχαν «ακινητοποιηθεί» επάνω σε συνθετικά σωματίδια. Οπως προέκυψε, το νέο υλικό μπορούσε να φιλτράρει αερόλυμα που περιείχε τον ιό αλλά και να καταστρέψει τις πρωτεΐνες-ακίδες μέσα σε 30 δευτερόλεπτα από τη στιγμή που ερχόταν σε επαφή μαζί τους.
Με βάση τη μελέτη, η μεμβράνη παρείχε προστασία ανώτερη από εκείνη που προσφέρουν οι μάσκες NK95, γεγονός που σημαίνει ότι είχε την ικανότητα να φιλτράρει τουλάχιστον το 95% των αερομεταδιδόμενων σωματιδίων.
«Οι μεμβράνες μας αποδείχθηκε ότι αποτελούν ένα υποσχόμενο σύστημα για τη δημιουργία μιας νέας γενιάς μασκών προσώπου καθώς και φίλτρων για τα συστήματα απολύμανσης του αέρα στους εσωτερικούς χώρους, που μπορεί να μειώσει σημαντικά τη μετάδοση του κορωνοϊού μέσω της απενεργοποίησης των πρωτεϊνών του ιού και της σύλληψης των αερομεταδιδόμενων σωματιδίων» κατέληξαν οι ερευνητές στη μελέτη τους.
ΔΙΑΓΝΩΣΗ
Τεστ αίματος μετράει σε 10 λεπτά τα εξουδετερωτικά αντισώματα

Η γραφική απεικόνιση του τεστ από την παρουσίασή του στην επιθεώρηση «Cell Reports Methods»
Μεγάλο τμήμα του παγκόσμιου πληθυσμού έχει πλέον κάποιον βαθμό ανοσίας στον SARS-CoV-2 είτε μέσω εμβολιασμού είτε εξαιτίας νόσησης με COVID-19 είτε λόγω ενός συνδυασμού και των δύο. Ωστόσο το μεγάλο ερώτημα παραμένει: Πόσο προστατευμένος ενάντια στον ιό παραμένει ο καθένας μας;
Ερευνητές από το Τεχνολογικό Ινστιτούτο της Μασαχουσέτης (ΜΙΤ) μπορούν, όπως ανέφεραν, να δώσουν πλέον απάντηση σε αυτό το φλέγον ερώτημα, καθώς ανέπτυξαν ένα εύκολο στη χρήση τεστ το οποίο μετρά σε δείγμα αίματος τα επίπεδα των εξουδετερωτικών αντισωμάτων ενάντια στον πανδημικό κορωνοϊό. Το νέο τεστ που παρουσιάστηκε στην επιθεώρηση «Cell Reports Methods» χρησιμοποιεί τον ίδιο τύπο τεχνολογίας στον οποίο βασίζονται τα περισσότερα rapid tests.
Η γρήγορη και εύκολη πρόσβαση σε ένα τέτοιου είδους τεστ μπορεί να βοηθήσει το κάθε άτομο να προσδιορίσει τι είδους προστατευτικά μέτρα πρέπει να λάβει ώστε να μη μολυνθεί με COVID-19, όπως το να λάβει άμεσα επιπλέον ενισχυτική δόση εμβολίου, σημείωσαν οι ερευνητές, οι οποίοι έχουν υποβάλει ήδη αίτηση για κατοχύρωση πατέντας της τεχνολογίας τους και αναζητούν συνεργασίες με εταιρείες κατασκευής διαγνωστικών τεστ ώστε να καταστήσουν εμπορικά διαθέσιμο το «τέκνο» τους.
Σύμφωνα με τον Χοτζούν Λι, κύριο συγγραφέα της μελέτης, ερευνητή στο Ινστιτούτο Koch για την Ολοκληρωμένη Ερευνα στον Καρκίνο του ΜΙΤ, «το τεστ αυτό μπορεί να κάνει τη μεγάλη διαφορά σε ό,τι αφορά τα άτομα που υποβάλλονται σε χημειοθεραπείες, τους ασθενείς που λαμβάνουν ανοσοκατασταλτικά φάρμακα για αυτοάνοσα νοσήματα, τους ηλικιωμένους ή οποιονδήποτε άλλο άνθρωπο ο οποίος δεν έχει καλή ανοσολογική απόκριση στα εμβόλια. Ολες αυτές οι ομάδες του πληθυσμού πιθανώς χρειάζεται να λάβουν νωρίτερα ενισχυτική δόση εμβολίου ή έχουν ανάγκη από περισσότερες δόσεις ώστε να επιτύχουν επαρκή προστασία».
Ευέλικτος σχεδιασμός
Το τεστ είναι έτσι σχεδιασμένο ώστε να μπορεί να γίνεται αντικατάσταση των πρωτεϊνών-ακίδων που εντοπίζει, γεγονός που θα επιτρέπει να τροποποιείται ώστε να ανιχνεύει την ανοσολογική απόκριση σε οποιαδήποτε υπάρχουσα ή μελλοντική παραλλαγή του SARS-CoV-2.
Πώς ακριβώς λειτουργεί όμως το σύστημα που ανέπτυξαν οι επιστήμονες του ΜΙΤ; Ανιχνεύει την ύπαρξη αντισωμάτων που μπλοκάρουν την περιοχή πρόσδεσης του υποδοχέα του SARS-CoV-2 (RBD) από το να προσδεθεί στον ACE2, τον υποδοχέα των ανθρωπίνων κυττάρων τον οποίο χρησιμοποιεί ο ιός για να εισέλθει εντός τους. Το πρώτο βήμα είναι η ανάμειξη ανθρώπινων δειγμάτων αίματος με ιική πρωτεΐνη RBD, η οποία έχει σημανθεί με μικροσκοπικά χρυσά σωματίδια που είναι ορατά όταν προσδένονται σε μια ειδική ταινία. Αφού περάσει ένα μικρό χρονικό διάστημα προκειμένου τα αντισώματα στο δείγμα να αλληλεπιδράσουν με την ιική πρωτεΐνη, λίγες σταγόνες από το δείγμα τοποθετούνται στην πλακέτα του τεστ που φέρει δύο γραμμές.
Η μία από τις δύο γραμμές έλκει τις ελεύθερες ιικές RBD πρωτεΐνες, ενώ η δεύτερη έλκει τις RBD που έχουν συλληφθεί από τα εξουδετερωτικά αντισώματα. Ενα ισχυρό σήμα από τη δεύτερη γραμμή του τεστ δείχνει υψηλά επίπεδα εξουδετερωτικών αντισωμάτων στο δείγμα. Υπάρχει και μια τρίτη γραμμή αναφοράς, η οποία ανιχνεύει τα ελεύθερα σωματίδια χρυσού επιβεβαιώνοντας ότι το διάλυμα έρευσε σωστά σε ολόκληρη την πλακέτα, άρα το τεστ είναι έγκυρο. Σημειώνεται ότι για τη διεξαγωγή του τεστ λαμβάνεται ένα πολύ μικρό δείγμα αίματος – λιγότερο από 10 μικρόλιτρα – και το αποτέλεσμα εξάγεται σε 10 λεπτά.
Ποιοτικός και ποσοτικός έλεγχος
Η συσκευή δεν δίνει όμως μόνο αποτελέσματα σχετικά με την παρουσία ή όχι των εξουδετερωτικών αντισωμάτων στο δείγμα. Μπορεί να συνδυαστεί με μια εφαρμογή στα έξυπνα κινητά τηλέφωνα προκειμένου να προσφέρει πιο ακριβή μέτρηση των επιπέδων αντισωμάτων. Η εφαρμογή αυτή μετρά την ένταση της κάθε γραμμής του τεστ και υπολογίζει την αναλογία της RBD πρωτεΐνης που αφορά τα εξουδετερωτικά αντισώματα προς την αναλογία της ιικής RBD πρωτεΐνης.
Οταν το αποτέλεσμα της αναλογίας είναι χαμηλό, μαρτυρεί ότι το άτομο πιθανώς χρειάζεται ενισχυτική δόση εμβολίου ή τη λήψη επιπλέον μέτρων προστασίας ώστε να αποφύγει τη μόλυνση.
Οι ερευνητές δοκίμασαν το τεστ σε δείγματα αίματος που συνελέγησαν από περίπου 60 άτομα που είχαν μολυνθεί με SARS-CoV-2 και 30 άτομα που δεν είχαν μολυνθεί με τον ιό. Οπως είδαν, το τεστ προσέφερε ανίχνευση των εξουδετερωτικών αντισωμάτων στα δείγματα των ατόμων που είχαν νοσήσει με COVID-19 με ακρίβεια παρόμοια εκείνης των υπαρχόντων εργαστηριακών τεστ.
Η ερευνητική ομάδα ελπίζει τώρα σε συνεργασίες με εταιρείες για την κατασκευή του τεστ σε μαζική κλίμακα καθώς και σε έγκριση χρήσης του από την αρμόδια Υπηρεσία Τροφίμων και Φαρμάκων των ΗΠΑ (FDA).
Εξέταση-εξπρές «διαβάζει» την κυτταρική ανοσία
Ενα νέο τεστ αίματος που αναπτύχθηκε από ερευνητική ομάδα του Ιατρικού Πανεπιστημίου της Βιέννης (MedUni Vienna) δείχνει την κυτταρική ανοσία ενός ατόμου στον SARS-CoV-2 μέσα σε μόλις 48 ώρες. Το τεστ που παρουσιάστηκε στην επιθεώρηση «Αllergy» αναμένεται να αποδειχθεί πολύτιμο για ευάλωτες ομάδες ασθενών που δεν αναπτύσσουν καλή αντισωματική απόκριση μετά από τον εμβολιασμό. Η ταχεία εξέταση μπορεί ακόμη να δείξει αν η ανοσία που έχει αναπτύξει ένα άτομο είναι το αποτέλεσμα εμβολιασμού ενάντια στον κορωνοϊό ή αποτέλεσμα λοίμωξης με την COVID-19.
Το νέο τεστ βασίζεται στην απόκριση των Τ κυττάρων σε τρία διαφορετικά μείγματα πεπτιδίων του SARS-CoV-2. Tα Τ κύτταρα αποτελούν σημαντικό τμήμα της κυτταρικής ανοσολογικής άμυνας καθώς εξολοθρεύουν τα κύτταρα που μολύνονται με τον κορωνοϊό και υποστηρίζουν την παραγωγή αντισωμάτων από τα Β κύτταρα.
«Σήμερα απαιτείται τουλάχιστον μια εβδομάδα για να πραγματοποιηθούν τέτοια τεστ, τα οποία μάλιστα διεξάγονται μόνο σε εξειδικευμένα εργαστήρια που διαθέτουν ειδικό εξοπλισμό. Αντιθέτως, το νεοαναπτυχθέν δικό μας τεστ διεξάγεται απευθείας στο δείγμα αίματος και δίνει αποτελέσματα μέσα σε μόλις 48 ώρες» εξήγησε ο επικεφαλής της μελέτης Γουίνφριντ Πικλ από το Κέντρο Παθοφυσιολογίας, Λοιμωξιολογίας και Ανοσολογίας του MedUni Vienna.
Από τον ερχόμενο Σεπτέμβριο το τεστ θα είναι διαθέσιμο στο Ινστιτούτο Ανοσολογίας του MedUni Vienna και θα είναι ιδιαιτέρως χρήσιμο για όσους δεν είναι σε θέση να παράγουν επαρκή επίπεδα αντισωμάτων ενάντια στον SARS-CoV-2.
Διάκριση ανοσίας από εμβολιασμό ή νόσηση
Μάλιστα η ανάλυση δειγμάτων αίματος από αναρρώσαντες από COVID-19, η οποία βασίστηκε σε μείγματα πεπτιδίων από τις πρωτεΐνες S- (ακίδα), M- (μεμβράνης) και NC- (νουκλεοκαψιδίου) του ιού, επέτρεψε στην ερευνητική ομάδα να ανιχνεύσει τις δύο αντι-ιικές κυτταροκίνες ιντερλευκίνη 2 (IL-2) και ιντερφερόνη-γάμμα σε μεγάλες ποσότητες, αλλά και την κυτταροκίνη ιντερλευκίνη 13 (ΙL-13) ως δείκτη της ανοσολογικής απόκρισης των Τ κυττάρων ενάντια στον SARS-CoV-2. H IL-13 ήταν επί μακρόν γνωστή ως δείκτης των αλλεργικών ανοσολογικών αντιδράσεων αλλά φαίνεται πλέον ότι παίζει ρόλο-«κλειδί» και στη μακροπρόθεσμη αντισωματική απόκριση.
Χρησιμοποιώντας τα τρία διαφορετικά μείγματα πεπτιδίων οι ερευνητές πέτυχαν επίσης να διαχωρίσουν σε ποιες περιπτώσεις η κυτταρική απόκριση ήταν αποτέλεσμα εμβολιασμού και σε ποιες νόσησης από COVID-19. Συγκεκριμένα, στα δείγματα από αναρρώσαντες εθελοντές εμφανιζόταν σημαντική παραγωγή κυτταροκινών και στα τρία πεπτιδικά μείγματα, ενώ στα δείγματα των εμβολιασμένων εθελοντών εμφανιζόταν αύξηση των κυτταροκινών μόνο στο πεπτιδικό μείγμα που αφορούσε την πρωτεΐνη S- (την πρωτεΐνη-ακίδα του ιού που στοχεύουν τα εμβόλια).
Η απόκριση των Τ κυττάρων αναλύθηκε επίσης 10 μήνες μετά τη λοίμωξη με τον SARS-CoV-2. Oπως προέκυψε, η κυτταρική απόκριση παρέμενε εξίσου ισχυρή με εκείνη που είχε μετρηθεί 10 εβδομάδες μετά τη λοίμωξη.
Το εύρημα αυτό, κατά τους ερευνητές, είναι σημαντικό, με δεδομένο ότι τα επίπεδα αντισωμάτων στο αίμα είχαν πέσει σημαντικά στο δεκάμηνο από τη νόσηση. Αυτή η μακροπρόθεσμη απόκριση των Τ κυττάρων μπορεί να προστατεύσει από σοβαρή νόσηση σε περίπτωση επαναλοίμωξης με τον πανδημικό κορωνοϊό, είναι το καταληκτικό αισιόδοξο μήνυμα της μελέτης.
Γρήγορο PCR με αποτελέσματα σε λιγότερο από μισή ώρα

Διπλό πλεονέκτημα για το PCR των ερευνητών του Κολούμπια είναι η ταχύτητα λήψης των αποτελεσμάτων και η φορητότητα της συσκευής
Μια νέα πλατφόρμα για ταχεία διεξαγωγή εξέτασης PCR η οποία δίνει αποτελέσματα σε 23 λεπτά ανέπτυξαν ερευνητές της Σχολής Μηχανικής στο Πανεπιστήμιο Κολούμπια της Νέας Υόρκης, σύμφωνα με δημοσίευσή τους στην επιθεώρηση «Nature Nanotechnology». Η πλατφόρμα αυτή μπορεί να χρησιμοποιηθεί για την ανίχνευση πλήθους ιών – όχι μόνο του SARS-CoV-2 αλλά και της γρίπης και άλλων ιογενών απειλών που απαιτούν ταχεία έγκυρη διάγνωση ώστε να μειωθεί η εξάπλωσή τους στον πληθυσμό.
Σύμφωνα με τους δημιουργούς της, η νέα γρήγορη PCR για την εφαρμογή της οποίας χρησιμοποιείται μια φορητή συσκευή που ζυγίζει λιγότερο από ένα κιλό (Rover PCR), μπορεί να εφαρμοστεί οπουδήποτε, χωρίς μάλιστα να απαιτείται εξειδικευμένο προσωπικό. «Στόχος μας ήταν να δημιουργήσουμε μια πλατφόρμα η οποία θα μπορεί να χρησιμοποιηθεί σε μέρη όπου απαιτείται γρήγορη εξαγωγή αποτελεσμάτων όπως τα φαρμακεία, οι σταθμοί των ΜΜΜ, οι εκδηλώσεις αλλά και οι εταιρείες» ανέφερε o Σαμ Σία, καθηγητής Βιοϊατρικής Μηχανικής στο Κολούμπια.
Το σύστημα που αναπτύχθηκε σε συνεργασία με τη Rover Diagnostics, μια νεοφυή επιχείρηση βιοτεχνολογίας η οποία ιδρύθηκε το 2018 από τον δρα Σία και τον ειδικό στην τεχνολογία Μαρκ Φασιάνο, βασίζεται στη χρήση τεχνικών προετοιμασίας των δειγμάτων οι οποίες αναπτύχθηκαν στο εργαστήριο του καθηγητή Σία σε συνδυασμό με μια νέα φωτοθερμική προσέγγιση (την αποκαλούμενη πλασμονική θερμοκυκλοποίηση) που βασίζεται σε νανοσωματίδια τα οποία ακτινοβολούνται από υπέρυθρο φως και εκλύουν θερμότητα. Η τεχνική αυτή επιταχύνει πολύ, κατά τους ερευνητές, τη διεξαγωγή του τεστ και την εξαγωγή αποτελεσμάτων.
Η ερευνητική ομάδα προχωρεί αυτή τη στιγμή στη δημιουργία ενός εμπορικού προϊόντος που θα ανιχνεύει τον SARS-CoV-2, τις παραλλαγές του αλλά και άλλους ιούς.
ΘΕΡΑΠΕΙΑ
Καινοτόμο φάρμακο για σοβαρή νόσηση
Μια αντιφλεγμονώδης ουσία φαίνεται ότι μπορεί να πολεμήσει τη συστηματική φλεγμονή και τις βλάβες στον εγκέφαλο σε νοσηλευόμενους ασθενείς με σοβαρή COVID-19, μειώνοντας σημαντικά τον κίνδυνο θανάτου. Αυτό έδειξε αμερικανική πολυκεντρική μελέτη που δημοσιεύθηκε στην επιθεώρηση «Science Translational Medicine».
Το φάρμακο με την κωδική ονομασία ΟΡ-101 δοκιμάστηκε σε τυχαιοποιημένη διπλά τυφλή κλινική δοκιμή φάσης 2 σε ασθενείς με σοβαρή COVID-19. Στη δοκιμή συμμετείχαν 24 ασθενείς από πέντε κλινικές των ΗΠΑ οι οποίοι έλαβαν είτε μια ενδοφλέβια δόση του ΟΡ-101 είτε εικονικό φάρμακο σε συνδυασμό με τη συμβατική θεραπεία αντιμετώπισης της νόσου τους.
«Το ΟΡ-101 είναι ένα καινοτόμο νανοθεραπευτικό φάρμακο το οποίο στοχεύει αποκλειστικά τα ενεργοποιημένα μακροφάγα καθώς και τα μικρογλοία, σημαντικά ανοσοκύτταρα του εγκεφάλου που εντοπίζουν πιθανές βλάβες και λοιμώξεις» εξήγησε ο κύριος συγγραφέας της μελέτης Ααρον Γκάζντον, επίκουρος καθηγητής στο Τμήμα Νευροχειρουργικής του Πανεπιστημίου του Τέξας στο Χιούστον.
Τα αποτελέσματα
Η υπερφλεγμονή που πυροδοτείται από τον SARS-CoV-2 αποτελεί κύρια αιτία σοβαρής COVID-19. Το ΟΡ-101 φάνηκε ότι ήταν ανώτερο του εικονικού φαρμάκου στη μείωση των δεικτών φλεγμονής καθώς και των δεικτών νευρολογικής βλάβης. Επιπροσθέτως ο κίνδυνος για μηχανική υποστήριξη της αναπνοής ή θάνατο στις 30 ως 60 ημέρες μετά την υποβολή στη θεραπεία ήταν 71% για τους ασθενείς που έλαβαν εικονικό φάρμακο αλλά μόλις 18% για τους ασθενείς που έλαβαν ΟΡ-101. Στις 60 ημέρες από τη θεραπεία 3 στους 7 ασθενείς που έλαβαν εικονικό φάρμακο και 14 στους 17 ασθενείς που έλαβαν ΟΡ-101 επιβίωσαν.
Σύμφωνα με τα δεδομένα της κλινικής δοκιμής, το ΟΡ-101 ήταν καλά ανεκτό από τους ασθενείς και μπορεί να αποτελέσει αποτελεσματική θεραπεία για τους νοσηλευομένους με βαριά COVID-19.
Ο δρ Γκάζντον παραδέχθηκε ότι η κλινική δοκιμή ήταν μικρού εύρους, τόνισε ωστόσο ότι φάνηκαν σημαντικές ενδείξεις οφέλους από τη λήψη του φαρμάκου. Συμπλήρωσε μάλιστα ότι η συγκεκριμένη θεραπεία πιθανότατα θα μπορεί να ωφελήσει και ασθενείς με άλλες νόσους που οδηγούν σε συστηματική φλεγμονώδη απόκριση, συμπεριλαμβανομένων διαφορετικών μορφών τραύματος του εγκεφάλου.
«Καθολική» απάντηση στον κορωνοϊό με μονοκλωνικά αντισώματα

Μια «καθολική» θεραπεία μονοκλωνικών αντισωμάτων η οποία φαίνεται να είναι αποτελεσματική ενάντια στον πανδημικό κορωνοϊό και σε όλες τις παραλλαγές του ανακάλυψαν ερευνητές του Πανεπιστημίου της Αλαμπάμα στις ΗΠΑ, σύμφωνα με δημοσίευσή τους στην επιθεώρηση «PLoS Pathogens».
Μάλιστα οι ερευνητές σημείωσαν ότι η θεραπεία δείχνει αποτελεσματικότητα και ενάντια στον ιό SARS-CoV που εμφανίστηκε στην Κίνα το 2002 προκαλώντας επιδημία οξέος αναπνευστικού συνδρόμου, καθώς και στον ιό ΜΕRS-CoV που εμφανίστηκε στη Σαουδική Αραβία το 2012 προκαλώντας ξέσπασμα του αποκαλούμενου αναπνευστικού συνδρόμου της Μέσης Ανατολής. Συγχρόνως φαίνεται αποτελεσματική και ενάντια σε δύο κορωνοϊούς που προκαλούν κοινό κρυολόγημα.
«Ο SARS-CoV-2 έχει προκαλέσει τις περισσότερες λοιμώξεις και θανάτους παγκοσμίως από όλους τους κορωνοϊούς. Οι νέες παραλλαγές του συνδέονται με κίνδυνο διαφυγής από το ανοσοποιητικό σύστημα ακόμα και σε εμβολιασμένους ή νοσήσαντες, ενώ υπάρχει και η πιθανότητα ανάδυσης άλλων γενετικώς διαφορετικών κορωνοϊών στο μέλλον που μπορούν να αποτελέσουν πανδημική απειλή» σημείωσε ένας εκ των κύριων συγγραφέων της μελέτης, ο αναπληρωτής καθηγητής του Τμήματος για τα Μεταδιδόμενα Νοσήματα στην Ιατρική Σχολή του Πανεπιστημίου της Αλαμπάμα Τζέιμς Κόμπι, και προσέθεσε: «Για όλους αυτούς τους λόγους η ανάπτυξη νέων θεραπευτικών και προφυλακτικών θεραπειών με καθολική δράση ενάντια στους κορωνοϊούς είναι ζωτικής σημασίας για να προστατεύσουμε την ανθρωπότητα από την τρέχουσα πανδημία αλλά και τις μελλοντικές επιδημίες ή πανδημίες από βήτα κορωνοϊούς».
Ο δρ Κόμπι και η υπόλοιπη ερευνητική ομάδα ανέλυσαν δείγματα πλάσματος αίματος αναρρωσάντων από COVID-19 και εντόπισαν ένα αντίσωμα «πρωταθλητή» το οποίο εξουδετέρωνε τόσο το αρχικό στέλεχος του SARS-CoV-2 (στέλεχος της Γουχάν) καθώς και τις παραλλαγές Βήτα, Γάμμα, Δέλτα, Εψιλον και Ομικρον.
Πού οφείλει το μονοκλωνικό αυτό αντίσωμα την υπερ-δράση του ενάντια σε τόσα στελέχη του SARS-CoV-2 αλλά και σε άλλους κορωνοϊούς; Στο ότι στοχεύει μια περιοχή της πρωτεΐνης-ακίδας των κορωνοϊών, την S2, η οποία είναι συντηρημένη σε όλους τους βήτα κορωνοϊούς ενώ την ίδια στιγμή είναι πολύ σημαντική προκειμένου ο ιοί να προσδένονται στα ανθρώπινα κύτταρα και να εισέρχονται εντός τους ώστε να τα μολύνουν.
Σημειώνεται ότι σήμερα τα εμβόλια και τα μονοκλωνικά αντισώματα ενάντια στον SARS-CoV-2 στοχεύουν σχεδόν στο σύνολό τους μιαν άλλη περιοχή της πρωτεΐνης-ακίδας, την περιοχή δέσμευσης του υποδοχέα (RBD) της υπομονάδας S1 – η συγκεκριμένη περιοχή βρίσκεται στην κεφαλή της πρωτεΐνης-ακίδας η οποία προεξέχει από την επιφάνεια του ιού (κάθε ιός έχει 20 ως 40 ακίδες). Η περιοχή RBD προκαλεί πολύ καλή ανοσολογική απόκριση, ωστόσο υφίσταται πολλές μεταλλάξεις, γεγονός που μπορεί να επιτρέψει στον ιό να διαφεύγει από τα αντισώματα.
Το αντίσωμα «πρωταθλητής» με την κωδική ονομασία 1249A8 hmAb έδειξε μάλιστα συνεργική δράση όταν χρησιμοποιήθηκε σε συνδυασμό με ένα άλλο προσφάτως ανακαλυφθέν αντίσωμα, γνωστό ως 1212Η7 (το οποίο στοχεύει την υπομονάδα S1) σε πειράματα σε χάμστερ. Και τα δύο αυτά αντισώματα έχουν μάλιστα τροποποιηθεί έτσι ώστε να έχουν μακροπρόθεσμη αποτελεσματικότητα – ακόμα και επί ένα έτος ή περισσότερο μετά τη χορήγησή τους. Το θεραπευτικό «κοκτέιλ» που χορηγείται μέσω της ρινικής οδού έδειξε ευρεία θεραπευτική δράση στα χάμστερ που είχαν νοσήσει με COVID-19 και οι ερευνητές ελπίζουν να περάσουν το συντομότερο δυνατόν σε κλινικές δοκιμές του σε ανθρώπους.
«Κοκτέιλ» απέναντι στα νέα στελέχη
Ερευνητές από το Πανεπιστήμιο του Κεντ στη Βρετανία και το Πανεπιστήμιο Γκέτε στη Φρανκφούρτη εντόπισαν νέες συνδυαστικές θεραπείες για την COVID-19, οι οποίες μπορούν να προσφέρουν καλύτερη προστασία ενάντια στις μελλοντικές παραλλαγές του SARS-CoV-2 και στις πιθανές επιδημίες που πιθανώς αυτές θα «γεννήσουν».
Η ερευνητική ομάδα εξέτασε την ευαισθησία των παραλλαγών Δέλτα και Ομικρον του ιού σε συνδυασμούς των τεσσάρων εγκεκριμένων αυτή τη στιγμή αντι-ιικών θεραπειών για την COVID-19 με ανασυνδυασμένη βηταφερόνη – μια ιντερφερόνη που παράγεται και φυσικά από τον ανθρώπινο οργανισμό και τον προστατεύει από ιογενείς λοιμώξεις.
Οι ερευνητές ανακάλυψαν, όπως ανέφεραν στην επιθεώρηση «Journal of Infection», ότι οι συνδυαστικές θεραπείες που δοκίμασαν σε καλλιέργειες κυττάρων ήταν πολύ αποτελεσματικές και πιθανώς μπορούν να μειώσουν τη δημιουργία νέων παραλλαγών του ιού.
Οπως σημείωσε ο καθηγητής Μάρτιν Μικέλις από το Πανεπιστήμιο του Κεντ που ήταν εκ των επικεφαλής της ερευνητικής ομάδας, «τα ευρήματα αυτά είναι συναρπαστικά και ελπίζουμε ότι θα βοηθήσουν να βελτιώσουμε τη θεραπεία των ευάλωτων ασθενών με COVID-19 και να αποφύγουμε κατά το δυνατόν τη δημιουργία ανθεκτικών στελεχών του ιού».
Σήμερα υπάρχουν τρία εγκεκριμένα αντι-ιικά φάρμακα για τη θεραπεία της COVID-19: η ρεμδεσιβίρη, η μολνουπιραβίρη και οι νιρματρελβίρη/ριτοναβίρη (Paxlovid). Επιπλέον η απροτινίνη αποτελεί ένα εγκεκριμένο αντι-ιικό φάρμακο του οποίου η αποτελεσματική δράση ενάντια στον SARS-CoV-2 αποδείχθηκε από την ερευνητική ομάδα στην οποία ανήκει η νέα μελέτη.
Με βάση τα ευρήματα της μελέτης ο συνδυασμός της βηταφερόνης με μολνουπιραβίρη, ριτοναβίρη και απροτινίνη ήταν πολύ αποτελεσματικότερος από τον συνδυασμό με ρεμδεσιβίρη.
Ο καθηγητής Χάιντριχ Σινάτι από το Πανεπιστήμιο Γκέτε υπογράμμισε ότι «αν τα ευρήματα αυτά επιβεβαιωθούν στους ανθρώπους, ελπίζουμε ότι αποτελεσματικότερες θεραπείες θα μας βοηθήσουν να μειώσουμε τον κίνδυνο ανάδυσης νέων επικίνδυνων παραλλαγών του SARS-CoV-2».



